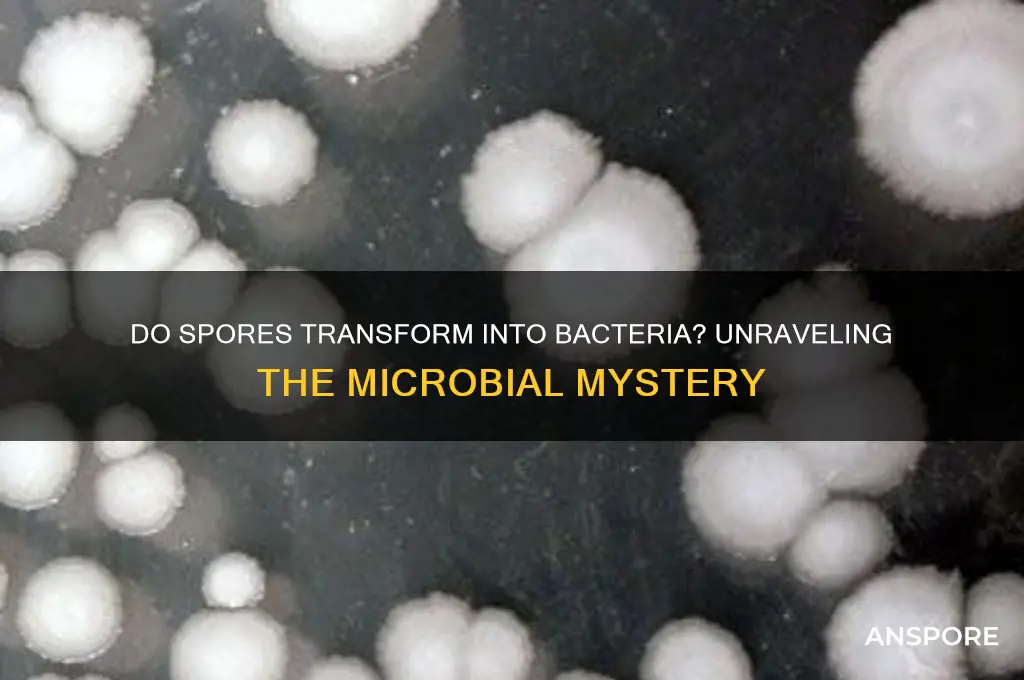
do spores become bacteria

The question of whether spores can become bacteria is a common one, often arising from confusion about the distinct biological roles and structures of these two entities. Spores are highly resistant, dormant structures produced by certain bacteria, fungi, and plants as a survival mechanism in harsh conditions. They are not living organisms themselves but rather a protective form that allows the parent organism to endure extreme environments. Bacteria, on the other hand, are single-celled microorganisms that actively grow, reproduce, and carry out metabolic processes. While bacterial spores can germinate under favorable conditions to produce new bacterial cells, spores themselves do not transform into bacteria; rather, they serve as a means for bacteria to survive and resume growth when conditions improve. Thus, spores are a stage in the bacterial life cycle, not a separate entity that becomes bacteria.
| Characteristics | Values |
|---|---|
| Spores and Bacteria Relationship | Spores do not become bacteria. Spores are a dormant, resilient form of certain bacteria, fungi, plants, or protists, not a separate organism that transforms into bacteria. |
| Origin of Spores | Spores are produced by bacteria (e.g., endospores in Bacillus and Clostridium), fungi, plants, and some protists as a survival mechanism. |
| Function of Spores | Spores serve as a survival structure, allowing organisms to withstand harsh conditions (e.g., heat, desiccation, radiation). |
| Bacterial Endospores | Bacterial endospores are highly resistant structures formed within certain bacterial cells (e.g., Bacillus anthracis), not a separate entity that becomes bacteria. |
| Germination Process | Under favorable conditions, bacterial endospores germinate to produce a new bacterial cell, but the spore itself does not "become" bacteria—it reactivates into a vegetative bacterial cell. |
| Fungal Spores | Fungal spores are reproductive structures that grow into new fungal organisms, not bacteria. |
| Plant Spores | Plant spores (e.g., from ferns or mosses) develop into new plant structures, not bacteria. |
| Key Distinction | Spores are a life stage or reproductive unit of specific organisms, not a precursor to bacteria. Bacteria are distinct prokaryotic cells that reproduce independently. |
| Scientific Consensus | There is no scientific evidence or mechanism by which spores transform into bacteria. They are separate biological entities with distinct roles and origins. |
Explore related products
What You'll Learn
- Spore Formation Process: How bacteria form spores as survival structures in harsh conditions
- Spore Germination: Conditions required for spores to activate and return to bacterial form
- Spore vs. Bacteria: Key differences in structure, function, and lifecycle stages
- Spore Resistance: How spores withstand extreme environments compared to bacterial cells
- Spore-to-Bacteria Transformation: Mechanisms and triggers for spores reverting to active bacteria

Spore Formation Process: How bacteria form spores as survival structures in harsh conditions
Spores are not bacterial cells themselves but rather specialized survival structures formed by certain bacteria under stress. This process, known as sporulation, is a remarkable adaptation that allows bacteria to endure extreme conditions such as heat, desiccation, and radiation. Unlike vegetative bacterial cells, which are metabolically active and vulnerable to environmental challenges, spores are dormant, highly resistant, and capable of surviving for years or even centuries. The transformation from a vegetative cell to a spore is a complex, energy-intensive process that ensures bacterial survival in harsh environments.
The spore formation process begins when a bacterium detects unfavorable conditions, such as nutrient depletion or extreme temperatures. In response, the cell initiates a series of genetic and morphological changes. For example, in *Bacillus subtilis*, a well-studged spore-forming bacterium, the process starts with the activation of the *spo0A* gene, which triggers the asymmetric division of the cell. This division results in the formation of a smaller compartment called the forespore and a larger compartment called the mother cell. The mother cell then engulfs the forespore, providing layers of protective coatings, including a thick peptidoglycan cortex and a proteinaceous coat. These layers are critical for the spore’s resistance to heat, chemicals, and enzymes.
One of the most fascinating aspects of spore formation is the dehydration of the forespore’s cytoplasm. During this stage, the spore reduces its water content to as low as 20–30% of its dry weight, which minimizes chemical reactions and damage from reactive oxygen species. Additionally, the spore accumulates dipicolinic acid (DPA), a calcium-chelating molecule that further stabilizes the spore’s DNA and proteins. This combination of dehydration and DPA accumulation is a key reason why spores can withstand conditions that would destroy vegetative cells.
To illustrate the practical implications of spore formation, consider the food industry. Spores of bacteria like *Clostridium botulinum* and *Bacillus cereus* are notorious for surviving standard cooking temperatures, posing a risk of foodborne illness if not properly managed. For instance, to ensure safety, canned foods are typically heated to 121°C (250°F) for at least 3 minutes, a process known as sterilization, to kill even the most heat-resistant spores. Similarly, in healthcare settings, autoclaves use steam under pressure at 121°C for 15–30 minutes to sterilize medical instruments, effectively destroying spores that could cause infections.
In conclusion, the spore formation process is a sophisticated survival mechanism that highlights bacterial adaptability. By understanding the steps involved—from genetic activation to protective layering and dehydration—we can better appreciate why spores are so resilient. This knowledge is not only crucial for scientific research but also for practical applications in food safety, medicine, and environmental management. While spores do not "become" bacteria in the sense of transformation, they do revert to vegetative cells when conditions improve, resuming growth and metabolic activity. This cycle underscores the dynamic nature of bacterial life and its ability to thrive in even the most challenging environments.
Can You See Botulism Spores? Unveiling the Invisible Threat
You may want to see also

Spore Germination: Conditions required for spores to activate and return to bacterial form
Spores, the dormant survival structures of certain bacteria, are remarkably resilient, enduring extreme conditions that would destroy their vegetative counterparts. However, their activation—a process known as spore germination—is not spontaneous. Specific environmental cues must align to trigger this transformation back into the bacterial form. Understanding these conditions is crucial for fields like food safety, medicine, and environmental science, where controlling spore behavior can prevent contamination or disease.
Triggering Factors: A Precise Recipe for Awakening
Spore germination requires a combination of physical and chemical signals. Temperature plays a pivotal role, with most bacterial spores activating within a range of 25°C to 40°C (77°F to 104°F). For instance, *Bacillus cereus* spores, a common food contaminant, germinate optimally at 30°C to 37°C. Nutrient availability is equally critical; spores detect specific amino acids, sugars, or salts that signal a favorable environment for growth. For example, *Clostridium botulinum* spores require a pH between 4.6 and 9.0 and the presence of L-alanine, a non-protein amino acid, to initiate germination. Hydration is another essential factor, as spores must absorb water to rehydrate their cellular machinery, typically requiring a water activity (aw) above 0.95.
Steps to Induce Germination: A Controlled Process
To activate spores in a laboratory or industrial setting, follow these steps:
- Heat Shock: Expose spores to a mild heat treatment (e.g., 70°C to 80°C for 10–15 minutes) to weaken their protective coat.
- Nutrient Addition: Introduce germinants like L-alanine, inositol, or glucose at concentrations of 10–100 mM, depending on the species.
- Optimal Temperature: Incubate the spores at their species-specific germination temperature, typically between 30°C and 37°C.
- Monitor pH and aw: Maintain a neutral pH (6.5–7.5) and ensure sufficient water availability to support metabolic reactivation.
Cautions and Challenges: Avoiding Unintended Activation
While controlled germination is useful in research, unintended spore activation poses risks in food preservation and healthcare. For instance, improper canning processes can fail to eliminate *Clostridium botulinum* spores, leading to botulism. Similarly, spores of *Bacillus anthracis*, the causative agent of anthrax, can survive in soil for decades, germinating upon inhalation into a host. To prevent activation, employ strategies like high-pressure processing (HPP), which inactivates spores without heat, or use chemical agents like hydrogen peroxide or peracetic acid to target spore coats.
Practical Applications: Harnessing Germination for Good
Understanding spore germination enables innovative solutions. In biotechnology, spores are used as delivery vehicles for probiotics or vaccines, activating only under specific conditions in the gut. In agriculture, spore-forming bacteria like *Bacillus subtilis* are applied as biofertilizers, germinating in soil to promote plant growth. For food safety, predictive models like the USDA’s Bacillus Spores Calculator help estimate spore survival under various processing conditions, ensuring products remain free of pathogens.
By mastering the conditions required for spore germination, we can both prevent harmful activations and harness their potential, turning a survival mechanism into a tool for progress.
Psilocybe Cubensis Spores: Surviving Extreme Cold Conditions Explained
You may want to see also

Spore vs. Bacteria: Key differences in structure, function, and lifecycle stages
Spores and bacteria, though often lumped together in discussions of microorganisms, are fundamentally distinct entities with unique structures, functions, and lifecycle stages. Spores are dormant, highly resistant structures produced by certain bacteria, fungi, and plants as a survival mechanism in harsh conditions. Bacteria, on the other hand, are single-celled organisms that actively metabolize and reproduce under favorable conditions. Understanding these differences is crucial for fields like microbiology, medicine, and environmental science, as it influences how we combat infections, preserve food, and study ecosystems.
Structurally, spores are remarkably resilient, encased in a thick, protective coat that shields them from extreme temperatures, desiccation, and chemicals. For example, bacterial endospores, such as those formed by *Clostridium botulinum*, can survive boiling water for hours. In contrast, most bacteria have a simpler structure, typically protected only by a cell wall and membrane, making them more vulnerable to environmental stressors. This structural disparity explains why spores can persist in soil, water, and even outer space for years, while most bacteria require specific conditions to survive.
Functionally, spores serve as a survival strategy, remaining metabolically inactive until conditions improve. Once activated, they germinate into vegetative cells, resuming growth and reproduction. Bacteria, however, are active agents of change in their environments, playing roles in nutrient cycling, fermentation, and pathogenicity. For instance, *Lactobacillus* bacteria ferment milk into yogurt, while *Escherichia coli* can cause foodborne illness. Spores do not perform these functions until they revert to their bacterial form, highlighting their passive role in ecosystems compared to the dynamic activity of bacteria.
The lifecycle stages of spores and bacteria further underscore their differences. Bacteria reproduce asexually through binary fission, a rapid process that doubles their population in as little as 20 minutes under optimal conditions. Spores, however, are not a reproductive stage but a protective one. They form in response to stress and remain dormant until conditions improve. For example, *Bacillus anthracis* forms spores in nutrient-depleted environments, which can later germinate into active bacteria when ingested by a host. This distinction is critical in medical contexts, as spore-forming pathogens like *Clostridioides difficile* require specific treatments to target both their vegetative and dormant forms.
In practical terms, these differences dictate how we address microbial challenges. Sterilization methods like autoclaving (121°C for 15–20 minutes) are necessary to kill spores, whereas many bacteria are eliminated by simpler methods like pasteurization (72°C for 15 seconds). In agriculture, understanding spore dormancy helps in managing soil health, while in medicine, distinguishing between bacterial infections and spore-related diseases guides treatment strategies. For instance, antibiotics like vancomycin target actively growing bacteria but are ineffective against dormant spores, necessitating additional measures like spore germinants or physical removal.
In summary, while spores and bacteria share microbial origins, their structural resilience, functional roles, and lifecycle stages diverge sharply. Spores are survival specialists, while bacteria are metabolic workhorses. Recognizing these differences empowers us to harness their benefits and mitigate their risks effectively, whether in preserving food, treating infections, or studying ecosystems.
Unraveling the Mystery: Why We Can't Communicate with Alien Spores
You may want to see also
Explore related products

Spore Resistance: How spores withstand extreme environments compared to bacterial cells
Spores, the dormant survival structures of certain bacteria, fungi, and plants, exhibit remarkable resilience in extreme environments where bacterial cells would perish. Unlike vegetative bacterial cells, which are metabolically active and vulnerable to harsh conditions, spores enter a state of suspended animation, minimizing water content and ceasing metabolic activity. This transformation allows them to endure temperatures exceeding 100°C, prolonged desiccation, and exposure to ionizing radiation—conditions that would denature bacterial proteins and disrupt cellular integrity within minutes. For instance, *Bacillus subtilis* spores can survive autoclaving at 121°C for 20 minutes, a process routinely used to sterilize laboratory equipment by killing vegetative bacteria.
The structural composition of spores underpins their extraordinary resistance. A thick, multilayered spore coat composed of keratin-like proteins acts as a protective barrier against enzymes, chemicals, and physical stressors. Beneath this lies the cortex, a specialized peptidoglycan layer that dehydrates during sporulation, further reducing spore permeability. The core, containing the spore’s DNA, is stabilized by dipicolinic acid (DPA), a calcium-chelating molecule that binds water molecules, preventing DNA damage from heat and radiation. In contrast, bacterial cells lack these specialized layers and rely on active repair mechanisms, which fail under extreme stress.
To illustrate the practical implications of spore resistance, consider food preservation. Spores of *Clostridium botulinum*, a pathogen that causes botulism, can survive boiling temperatures, necessitating pressure canning at 121°C for low-acid foods to ensure safety. Bacterial cells, even those of similar species, are eradicated at much lower temperatures, highlighting the spore’s superior survival strategy. This distinction is critical for industries like food processing, where understanding spore resistance informs sterilization protocols to prevent contamination.
While spores are nearly indestructible in their dormant state, they are not invincible. Prolonged exposure to extreme conditions, such as UV radiation or strong oxidizing agents, can eventually degrade spore coats and damage DNA. However, their ability to revert to vegetative cells when conditions improve—a process called germination—ensures their ecological persistence. This dual nature of spores—dormant resilience and active adaptability—sets them apart from bacterial cells, which lack such a robust survival mechanism.
In summary, spores withstand extreme environments through structural and biochemical adaptations that bacterial cells cannot replicate. Their ability to halt metabolism, fortify cellular structures, and protect genetic material enables survival in conditions lethal to vegetative bacteria. This resistance is not absolute but is sufficient to ensure long-term persistence in hostile environments, making spores a fascinating subject for both scientific inquiry and practical applications in industries ranging from food safety to astrobiology.
Can HEPA Filters Effectively Remove Spores from Indoor Air?
You may want to see also

Spore-to-Bacteria Transformation: Mechanisms and triggers for spores reverting to active bacteria
Spores, the dormant survival forms of certain bacteria, are renowned for their resilience against extreme conditions. However, under specific environmental cues, these inert structures can revert to active, metabolically vibrant bacterial cells. This process, known as spore germination, is not a transformation into a different organism but rather a reactivation of the bacterium’s metabolic machinery. Understanding the mechanisms and triggers behind this reversion is crucial for fields like microbiology, medicine, and biotechnology.
Mechanisms of Spore Germination: A Step-by-Step Process
Germination begins with the sensing of nutrient signals, such as amino acids, sugars, or purine nucleosides, which bind to specific receptors on the spore’s outer layers. For instance, *Bacillus subtilis* spores require a combination of L-valine, purine nucleosides, and potassium ions to initiate germination. Once triggered, the spore’s cortex, a thick layer of peptidoglycan, is degraded by enzymes like cortex-lytic enzymes (CLEs), allowing water to rehydrate the core. This is followed by the release of dipicolinic acid (DPA), a calcium-chelating molecule that stabilizes the spore’s DNA, and the breakdown of the spore coat. Finally, the cell resumes metabolic activity, transitioning into a vegetative bacterium capable of growth and division.
Environmental Triggers: What Awakens the Dormant Giant?
Spores remain dormant until specific environmental conditions signal favorable growth opportunities. Nutrient availability is the primary trigger, but other factors, such as temperature shifts, pH changes, and osmotic pressure, play critical roles. For example, *Clostridium botulinum* spores germinate optimally at temperatures between 25°C and 37°C, while *Bacillus anthracis* spores require specific amino acids like L-alanine. In industrial settings, controlling these triggers is essential to prevent contamination, as spores can survive sterilization processes and germinate when conditions improve.
Practical Implications: Harnessing and Halting Spore Reversion
In biotechnology, understanding spore germination allows for the controlled activation of bacteria in processes like probiotic production or biofertilizer development. For instance, *Bacillus thuringiensis* spores are used in agriculture, and their germination can be optimized by pre-treating soil with specific nutrients. Conversely, in food preservation and healthcare, preventing spore germination is critical. Techniques like high-pressure processing (HPP) or the use of antimicrobial agents that target germination receptors can inhibit reversion. For example, nisins, a class of antimicrobial peptides, have been shown to inhibit *Bacillus cereus* spore germination at concentrations as low as 50 μg/mL.
Comparative Analysis: Spore Germination Across Species
Different bacterial species exhibit unique germination requirements, reflecting their ecological niches. While *Bacillus* and *Clostridium* spores rely on nutrient-based triggers, others, like *Sporosarcina* spp., may require specific environmental stresses. This diversity highlights the adaptability of spores as survival strategies. For instance, soil-dwelling *Bacillus* species often germinate in response to root exudates, while *Clostridium* spores in the gut may require bile salts for activation. Such species-specific mechanisms underscore the importance of tailored approaches in both harnessing and combating spore reversion.
Takeaway: Balancing Activation and Inhibition
Spore-to-bacteria transformation is a finely tuned process governed by environmental cues and molecular mechanisms. Whether the goal is to activate spores for beneficial applications or inhibit their germination to prevent contamination, understanding these triggers is key. Practical tips include using nutrient-specific formulations to control germination in biotechnological processes and employing targeted antimicrobial strategies in food safety and medicine. By mastering these mechanisms, we can leverage the resilience of spores while mitigating their risks.
Can Rain Bring Mold Spores Indoors Through Open Windows?
You may want to see also
Frequently asked questions
Spores are not bacteria themselves but are a dormant, highly resistant form produced by certain bacteria (e.g., Bacillus and Clostridium) and fungi. Under favorable conditions, bacterial spores can germinate and develop into active bacterial cells.
No, fungal spores cannot turn into bacteria. Fungal spores are reproductive structures specific to fungi, while bacteria are entirely different organisms. They do not transform into one another.
No, not all spores can become bacteria. Only bacterial spores, such as those from Bacillus or Clostridium, can germinate into bacterial cells. Fungal spores and plant spores have different functions and do not develop into bacteria.































